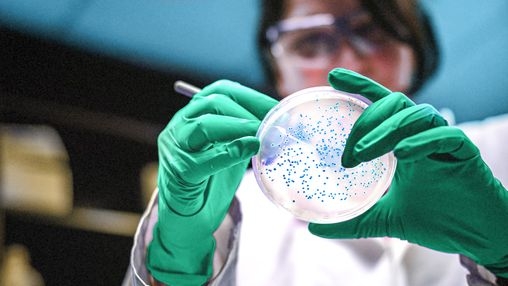
IMG_256

Recent developments in medical research are creating more targeted treatment possibilities for cervical cancer, offering patients a tailored approach to care. By focusing on the unique features of cancer cells, these therapies aim to improve treatment success while limiting unwanted side effects. These advancements illustrate a broader trend in oncology, reflecting the movement toward individualized therapies designed around each patient’s specific condition.
Understanding Cervical Cancer and the Basis for Targeted Approaches
Cervical cancer begins in the epithelial cells of the cervix, often preceded by pre-cancerous changes. Its progression is closely tied to persistent infections with high-risk strains of human papillomavirus. While screening programs and vaccines have reduced the overall incidence, advanced cases still present significant therapeutic challenges. A deeper understanding of the molecular mechanisms that fuel cervical cancer has opened the door to more precise treatment strategies. These approaches are designed to attack malignant cells directly by focusing on abnormal molecules or signaling pathways that drive disease progression.
The Development of Targeted Therapy in Cervical Cancer
For many years, surgery, radiation, and chemotherapy formed the standard treatment pathway for cervical cancer. Although effective in many cases, these methods can harm healthy tissue and cause considerable side effects. Targeted therapy represents a shift toward precision medicine, where treatments specifically disrupt the molecular mechanisms that sustain tumor growth. By focusing on receptors, proteins, or genetic mutations unique to cancer cells, this method delivers a more refined and personalized treatment option that minimizes unnecessary damage.
Mechanisms Behind Targeted Treatment
The principle of targeted therapy is to interrupt biological processes essential for tumor survival and spread. Cervical cancer cells may demonstrate overactive receptors or enzymes, making them susceptible to drugs that inhibit these targets. Blocking signaling receptors can disrupt the pathways that enable tumor growth, while strategies that limit angiogenesis can reduce the tumor’s blood supply and slow its expansion. By concentrating on these defined mechanisms, targeted therapies aim to improve effectiveness while reducing widespread toxicity.
Personalized Medicine and Biomarker Use
The effectiveness of targeted therapy depends on identifying biomarkers that indicate which patients are likely to benefit. Biomarkers may include specific gene mutations, protein expression patterns, or signaling abnormalities. Advanced genomic and proteomic testing provides clinicians with detailed insights into each patient’s tumor profile. This analysis allows for personalized treatment selection, ensuring therapies are aligned with the unique biology of the cancer. As a result, patients may experience better treatment responses with fewer adverse effects.
Benefits and Challenges of Targeted Approaches
A key strength of targeted therapy is its ability to treat cancer more selectively, sparing healthy cells and reducing common side effects associated with traditional treatments. It also offers hope for patients who have not responded to or cannot tolerate conventional therapies.
Nonetheless, there are obstacles. Cancer cells can develop resistance, either through mutations or by activating alternate pathways to survive. While overall toxicity may be lower, unique side effects may arise and require monitoring. Cost and access to advanced diagnostic testing are also important considerations, as successful implementation depends on specialized infrastructure and expertise.
Combining Targeted Therapy with Other Treatments
Research increasingly supports combining targeted therapies with other treatment methods such as immunotherapy, chemotherapy, and radiation. The goal is to achieve a synergistic effect, improving treatment outcomes while reducing the likelihood of resistance. For instance, combining molecularly targeted agents with immune checkpoint inhibitors may help the immune system recognize and attack tumor cells more effectively. Such integrative strategies represent a promising direction in cervical cancer management.
Future Research and Opportunities
The field of targeted therapy for cervical cancer continues to expand. Current studies aim to discover new molecular targets and deepen the understanding of tumor signaling networks. Clinical trials are testing new agents that interfere with critical biological pathways, while ongoing research is identifying additional biomarkers to predict treatment success. Advances in genomic analysis, bioinformatics, and non-invasive diagnostic tools are playing an important role in refining therapy options and detecting resistance earlier.
Progress will depend on collaboration across disciplines, combining oncology, molecular biology, and computational science. Continued research is expected to produce more precise and effective therapies, offering new hope to patients with advanced cervical cancer.
Overcoming Barriers to Clinical Application
Despite promising results, implementing targeted therapies in practice requires addressing certain challenges. Training for healthcare providers in molecular diagnostics and precision oncology is essential to ensure treatment decisions are evidence-based and up to date. Financial barriers, particularly in regions with limited resources, must also be considered. Healthcare systems and regulatory bodies are working to create guidelines that ensure safe, equitable, and effective use of targeted treatments.
Conclusion
Targeted therapy marks a significant step forward in cervical cancer treatment. By applying molecular insights, it offers patients more individualized, effective, and tolerable care options. While challenges such as resistance, cost, and accessibility remain, the ongoing evolution of this approach highlights its potential to reshape the future of cervical cancer management and improve patient outcomes worldwide.